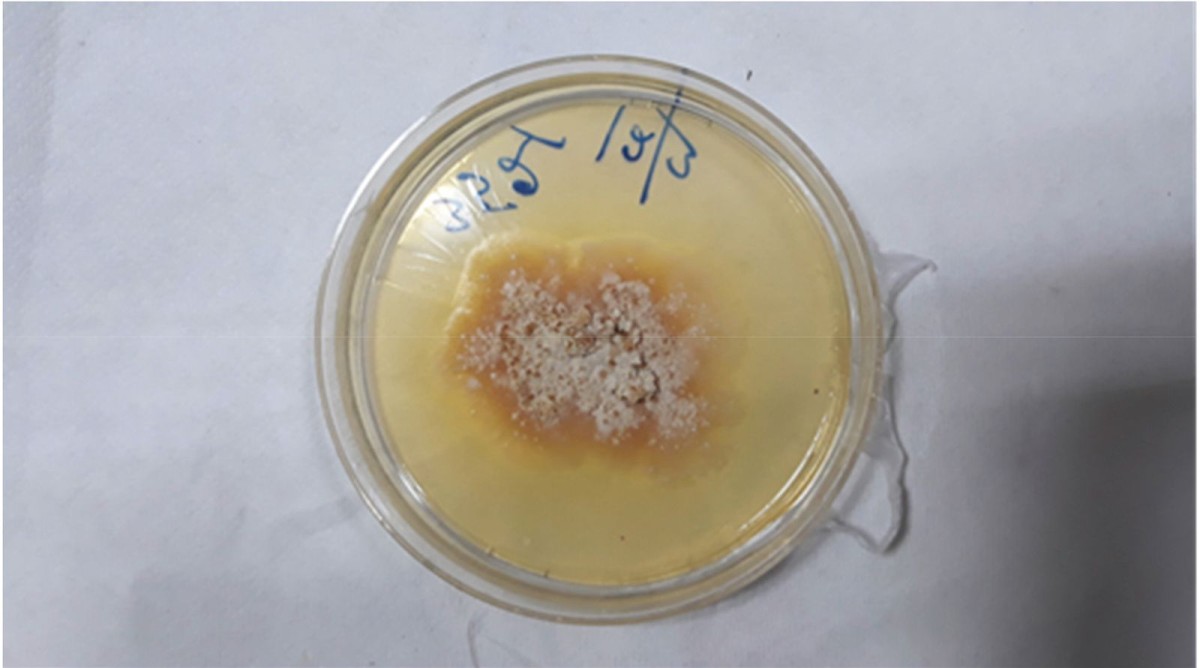
odessana ropa

Chondrostereum purpureum zainfekował człowieka w Indiach
Zabójczy dla roślin grzyb zaraził człowieka i spowodował u niego objawy grypopodobne. Zdaniem naukowców i lekarzy z Indii to pierwszy taki przypadek na świecie. Wcześniej nie odnotowano przypadku, w którym grzyb atakujący rośliny był w stanie to zrobić. Co ciekawe, sprawę opisano dopiero teraz, pomimo że zdarzenie miało miejsce dwa lata temu.
Chondrostereum purpureum powoduje chorobę srebrzystości liści u roślin, najczęściej drzew i u pewnych gatunków róż. Rozprzestrzeniany przez unoszące się w powietrzu zarodniki grzyb stopniowo zmienia kolor liści na srebrny i często prowadzi do obumierania flory.
Sprawdź: W USA ludzi terroryzuje czarny grzyb, która żywi się whiskey
Objawy jak przy grypie
Zarażonym był 61-letni mężczyzna, leczony w szpitalu wielospecjalistycznym Consultant Apollo w Kalkucie przez aż trzy miesiące. W tym czasie doświadczał takich objawów jak kaszel, zmęczenie, trudności w połykaniu i ochrypły głos. Co ważne, zainfekowany był mykologiem, który pracował na co dzień z grzybami.
Badania wykonane w szpitalu wykazały, że infekcja spowodowała ropień okołotchawiczy w szyi mężczyzny, częściowo blokując jego drogi oddechowe. Lekarze odessali ropę, a mężczyźnie przepisano lek przeciwgrzybiczy na dwa miesiące.
W przeciwieństwie do ludzi uważanych za najbardziej podatnych na infekcje grzybicze, o których wiadomo, że działają międzygatunkowo, takie jak osoby z rakiem, HIV, chorobami układu oddechowego i przeszczepami narządów, mężczyzna nie miał historii żadnych tego rodzaju chorób.
Mężczyzna wrócił do pełni sił
Medycy, którzy leczyli poszkodowanego, przekazali, że przypadek mężczyzny „rodzi poważne pytania” dotyczące zdolności patogenów roślinnych do wywoływania chorób u zdrowych ludzi i zwierząt.
Informacje opublikowano w dzienniku Medical Mycology Case Reports. Doniesiono, że po dwóch latach od zdarzenia mężczyzna czuje się dobrze.
Przyszłość rodem z The Last of Us
Szacuje się, że na świecie istnieją miliony gatunków grzybów. Ludzkość zna tylko około 150 000. Nieliczne, które atakują zarażać ludzi, robią to, ponieważ radzą sobie z temperaturą ciała na poziomie 37 stopni Celsjusza. W tym kontekście istnieją poważne obawy, że w miarę ocieplania się Ziemi w wyniku zmian klimatu, znane i nieznane grzyby mogą stać się potencjalnym zagrożeniem dla ludzkości.
Źródło: Sky, zdj. tyt. serial The Last of Us